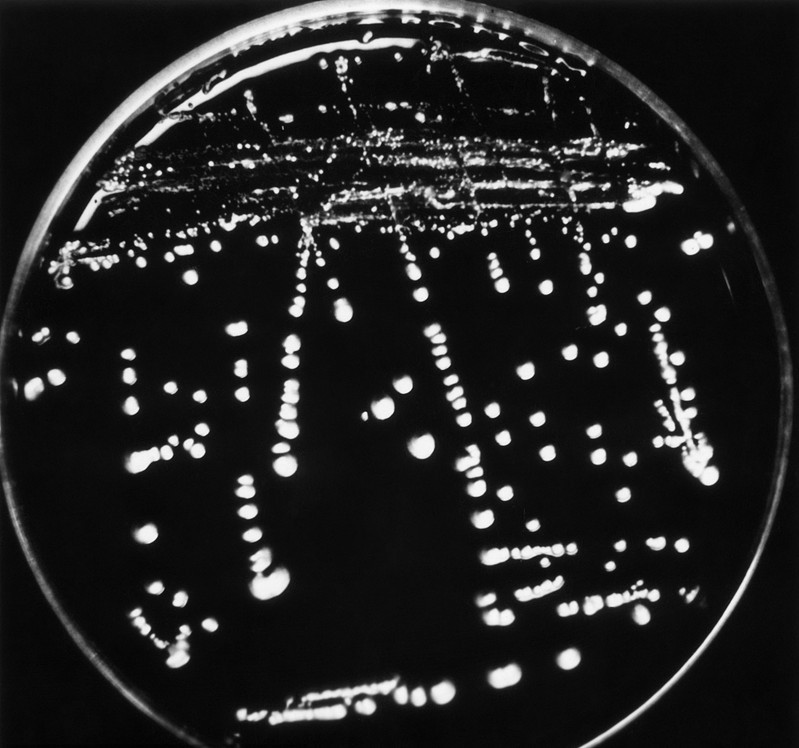
女性感染念珠菌有什么症状吗,念珠菌吃什么水果最好

超过80%的女性都曾感染念珠菌!一旦感染不重视,转化为念珠菌菌血症,便有极高的死亡率!水果会助长念珠菌在体内增生,当你开始实行人体平衡饮食,只可以吃很酸的水果,例如:柠檬、浆果,也可以喝不加糖的石榴汁、蔓越莓汁、黑醋栗汁,这些都是酸味或酸的水果,糖分低就不会导致念珠菌增生,以此反观其他水果,都太甜了。
水果很快就会通过消化系统,在胃部停留的时间通常不超过30分钟,接着进入小肠继续消化,但如果跟其他食物一起吃(如蛋白质或淀粉),就要花3至5小时,或者更久的时间消化。水果延迟消化就会开始发酵,身体便无法好好吸收水果的营养,更重要的是,这会形成念珠菌增生的绝佳环境,因为水果发酵所产生的糖分,会成为念珠菌的食物。
虽然水果最好单独食用,但只要搭配合适的食物,酸味水果仍可跟蛋白质脂肪食物一起吃,如酸奶、坚果或种子。比方草莓汁、蓝莓汁或石榴汁,都可以跟酸奶一起吃,或是搭配少量浸泡催芽的葵花籽食用。

等到健康情形改善了,就可以吃更多种类的水果,但仍须是酸味的水果,如葡萄柚和奇异果,这些也是低糖的水果,因为够酸,因此通常不会导致念珠菌症状。反正大家记住了,比较甜的水果,便是含有太多糖分。
早上吃甜水果 伤害肾上腺
只有在早晨睡醒时才算是真正的空腹,这是吃蓝莓等水果的最佳时间。早晨吃甜的水果会伤害肾上腺,所以千万不要犯一个常见的错误,那就是念珠菌感染还没完全康复,身体生态还没复原,就急着吃更多种类的食物,尤其是甜味的食物。
如果没有身体生态失衡的问题,酸味的水果可能是你理想的早餐,因为内含大量的水分,而身体休眠一整晚都没有喝水,正好很需要补充水分。因为身体脱水的缘故,我们强烈建议起床后,吃酸味水果之前,先喝几杯水。在第二杯水中加点柠檬汁,可是自古以来刺激大肠蠕动的方法。

不加糖的黑醋栗汁也有刺激食欲和缓解肠胃不适的效果,建议贫血患者饮用,而且也富含维生素C,是绝佳的抗氧化剂,也可以滋养肾上腺。我们都很爱黑醋栗汁,因为只要几克,就可以给人满满的活力。
这项定律有一个例外,那就是柠檬和动物性蛋白质可以一起吃,比如在烤鲑鱼上挤一点柠檬汁,就可以帮助消化,平衡扩张和收缩。